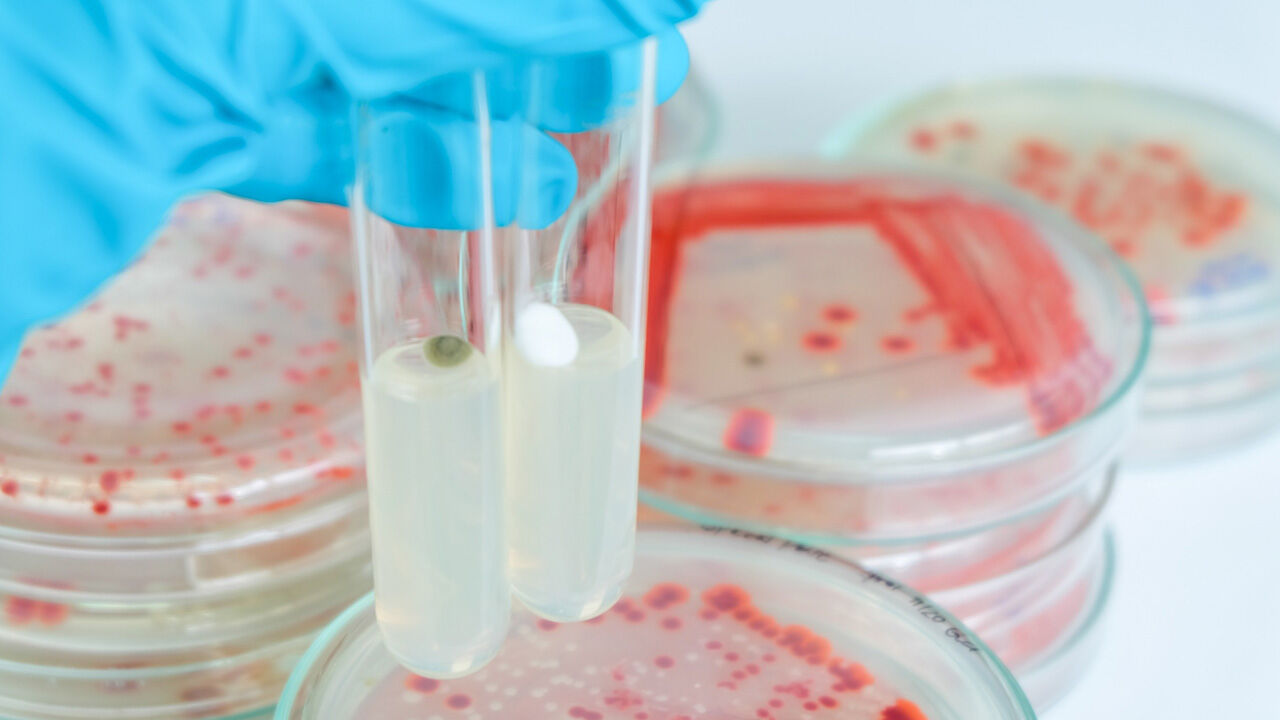
İshal ve kusma vakaları acilleri doldurdu! Çocuklar ve bağışıklığı düşük olanlar tehlikede - 1. Resim

İshal ve kusma vakaları acilleri doldurdu! Çocuklar ve bağışıklığı düşük olanlar tehlikede

Son günlerde artan mide bağırsak şikâyetleri yüzünden hastane acillerinde yoğunluklar yaşanıyor. Uzmanlar uyarıyor: Temizliğinden emin olmadığınız suya girmeyin, gıda hijyenine dikkat edin!..
ZİYNETİ KOCABIYIK'IN HABERİ - Sıcakların artmasıyla birlikte havuzdan ve denizden bulaşan bakteri ve virüslere bağlı gelişen ateş, mide bulantısı, kusma, karın ağrısı ve ishal vakalarında artışlar yaşanıyor. Göle, denize ya da havuza girdikten sonra şiddetli kusma yaşayan kişiler hastane acillerini doldururken, uzmanlar “Temizliğinden emin olmadığınız denize ve her gün klor kontrolü yapıldığı ilan edilmeyen havuza sakın girmeyin. Faturası ağır olabilir” uyarısında bulunuyor.
DENİZDE KOLİ BASİLİ ÖN PLANDA
Kirli sulardaki en önemli hastalık yapıcı etkenin halk arasında koli basili olarak bilinen Escherichia coli bakterisi olduğunu söyleyen Ankara Üniversitesi Tıp Fakültesi Enfeksiyon Hastalıkları AD öğretim üyesi Prof. Dr. İsmail Balık “Kusma, dışkıda kan, mide krampları ve ishalle kendini gösteren koli basilinin bazı alt tipleri hayatı tehdit eden hastalıklara da sebep olabilir” dedi.
Memelilerin kalın bağırsaklarında yaşayan ve dışkı yoluyla bulaşan koli basili havuz ve denizdeki kirliliği kolayca tespit etmeye yarayan bir test olarak da kullanılır. E. coli’nin tespit edildiği sularda, mide bağırsak enfeksiyonları ve yaz ishalleri yapabilecek diğer etkenlerin de olabileceğini ifade eden Prof. Dr. Balık “Çeşme suyu, havuz ya da deniz suyunda koli basili bulunuyorsa, bu sulara dışkı karıştığı anlamına gelir. Eğer bir sahilde havuz suyunda koli basili varsa bu denize girmek risktir. Plajın bulunduğu yerdeki belediyelerin suyun temizliğini ölçerek, mide ve bağırsak hastalıklarına yol açan etkenler açısından temiz olduğunu göstermesi gerekir” açıklamasını yaptı.
HAVUZUN KLOR DÜZEYİ DÜŞMEMELİ
Havuzların da her gün düzenli olarak klorlama kontrolünün yapılmış olması gerektiğine dikkat çeken Prof. Dr. Balık “Havuzların kenarında bulunan ve günlük sıcaklık, havuz suyu sıcaklığını belirten ışıklı tabelalarda havuzun klor düzeyi de belirtilmiş olmalıdır. Havuza girerken duş alınması ya da en azından ayakların daha yoğun klorlu bir bölüme sokularak havuza girilmesi ile virüs ve bakterilerle bulaşan hastalıkların havuzlardan yayılmasını engellenir” diye konuştu.
KOLERA VE TİFO DA BULAŞIYOR
Kirli sulardan ve çiğ yenilen gıdalardan ağız yoluyla alınan ve mide bağırsak hastalıkları, besin zehirlenmesi yapan etkenlerin hepsinin bulaştığını vurgulayan Prof. Dr. Balık “Bunlar arasında tifo, dizanteri, kolera, koli ve stafilokok gibi bakterilere bağlı besin zehirlenmeleri ya da bağırsak enfeksiyonları, nörovirüs gibi virüslere bağlı yine bulantı ve kusma ile seyreden hastalıkları sayabiliriz” dedi.
DENİZE GİRMEDEN ÖNCE MUTLAKA BU SİTEYE BAKIN!
Sağlık Bakanlığı Halk Sağlığı Genel Müdürlüğü, Yüzme Suyu Takip Sistemi ile vatandaşın korunması, sudaki kirleticilere karşı tehlikenin önlenmesi maksadıyla sağlık müdürlükleri aracılığıyla deniz ve göl kıyısındaki yerleşimlerde sezon boyunca yüzme suyu kalitesini bakteriyolojik açıdan izliyor. Elde edilen bilgiler, bakanlığın internet sitesinde yayınlanıyor. Vatandaşların denize girmeden önce yüzme alanları bilgi sistemine mutlaka bakması, yüzeceği plajdaki Escherichia Coli (Koli basili) ve İnstentinal Enterekok (Bakteri) miktarını öğrenip, denize girip girmemeye karar vermesi gerektiği tavsiye ediliyor. >>https://yuzme.saglik.gov.tr/
SEBZE VE MEYVEYİ SİRKELİ SUYA KOYUN
Yaz aylarında sıcakların artmasıyla birlikte gıdanın hijyen zincirinin bozulmasının, yiyecek ve içeceklerle bulaşan mide bağırsak enfeksiyonlarının görülme ihtimalini artırdığını da vurgulayan Prof. Dr. İsmail Balık şu ifadeleri kullandı: “Besin zehirlenmeleri daha çok bulantı ve kusma ön planda olan şikâyetler yapar. Bağırsak enfeksiyonlarında ise ateşli ya da ateşsiz ishal ön planda olur. Bazı bakterilerin toksinleri de bulantı ve kusma ile seyreden ancak ishal ön planda olmayan mide rahatsızlığı yapabilir.
Özellikle çiğ yenen sebze ve meyvelerin iyi yıkanmamış, klorlu ya da sirkeli suda bekletilmemiş olması bulaşma riskini artırır. Diğer taraftan kıyma, krema, tavuk ve tavuk ürünleri, gıda hijyeni açısından yaz aylarında çok kolay bakteri üreten gıdalardır. Vatandaşın bozulduğundan kuşkulandıkları veya dışarıda sıcak ortamda kaldığını düşündükleri hiçbir gıdayı tüketmemesi gerekir. Ayrıca bozuk gıdanın buzdolabına konması riskini ortadan kaldırmaz!”
YAZIN ELİNİZİ AĞZINIZA GÖTÜRMEYİN
Bazen gıdalar bozulsa bile tadı ve kokusunun hiç değişmediğini ve bunların tüketilmesi durumunda besin zehirlenmesinin meydana gelebileceğini belirten Prof. Dr. Balık “Gıda zehirlenmesi yapan bazı toksinler gıdanın tadını etkilemediği için gıdanın bozulduğunu anlamak mümkün olmayabilir. Ayrıca yaz boyunca ellerin bol sabunlu su ile yıkanmasına dikkat edilmelidir. Yemek yemeden, sigara içmeden önce mutlaka eller yıkanmalıdır. Ellerinizi ağzınıza götürme alışkanlığınız varsa yazın bu hareketlerden kaçının” dedi.






